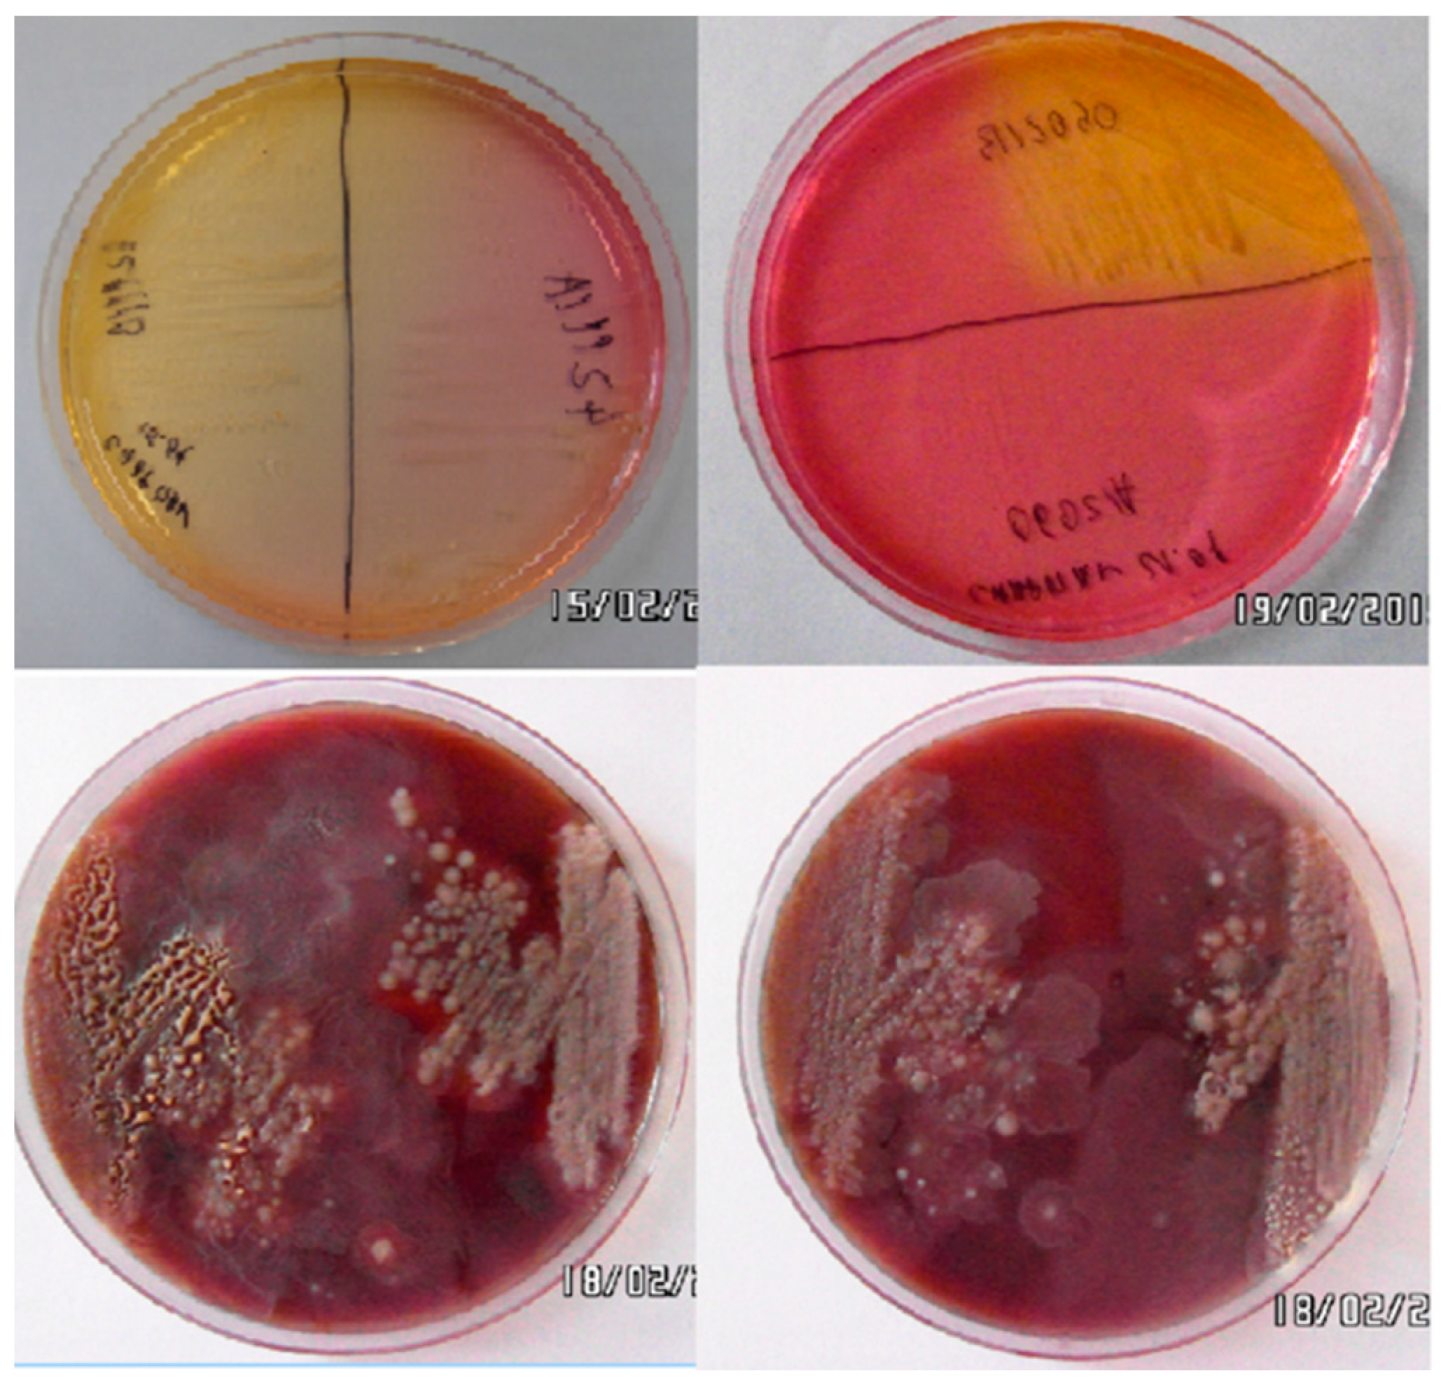
Animals 14 00683 g001
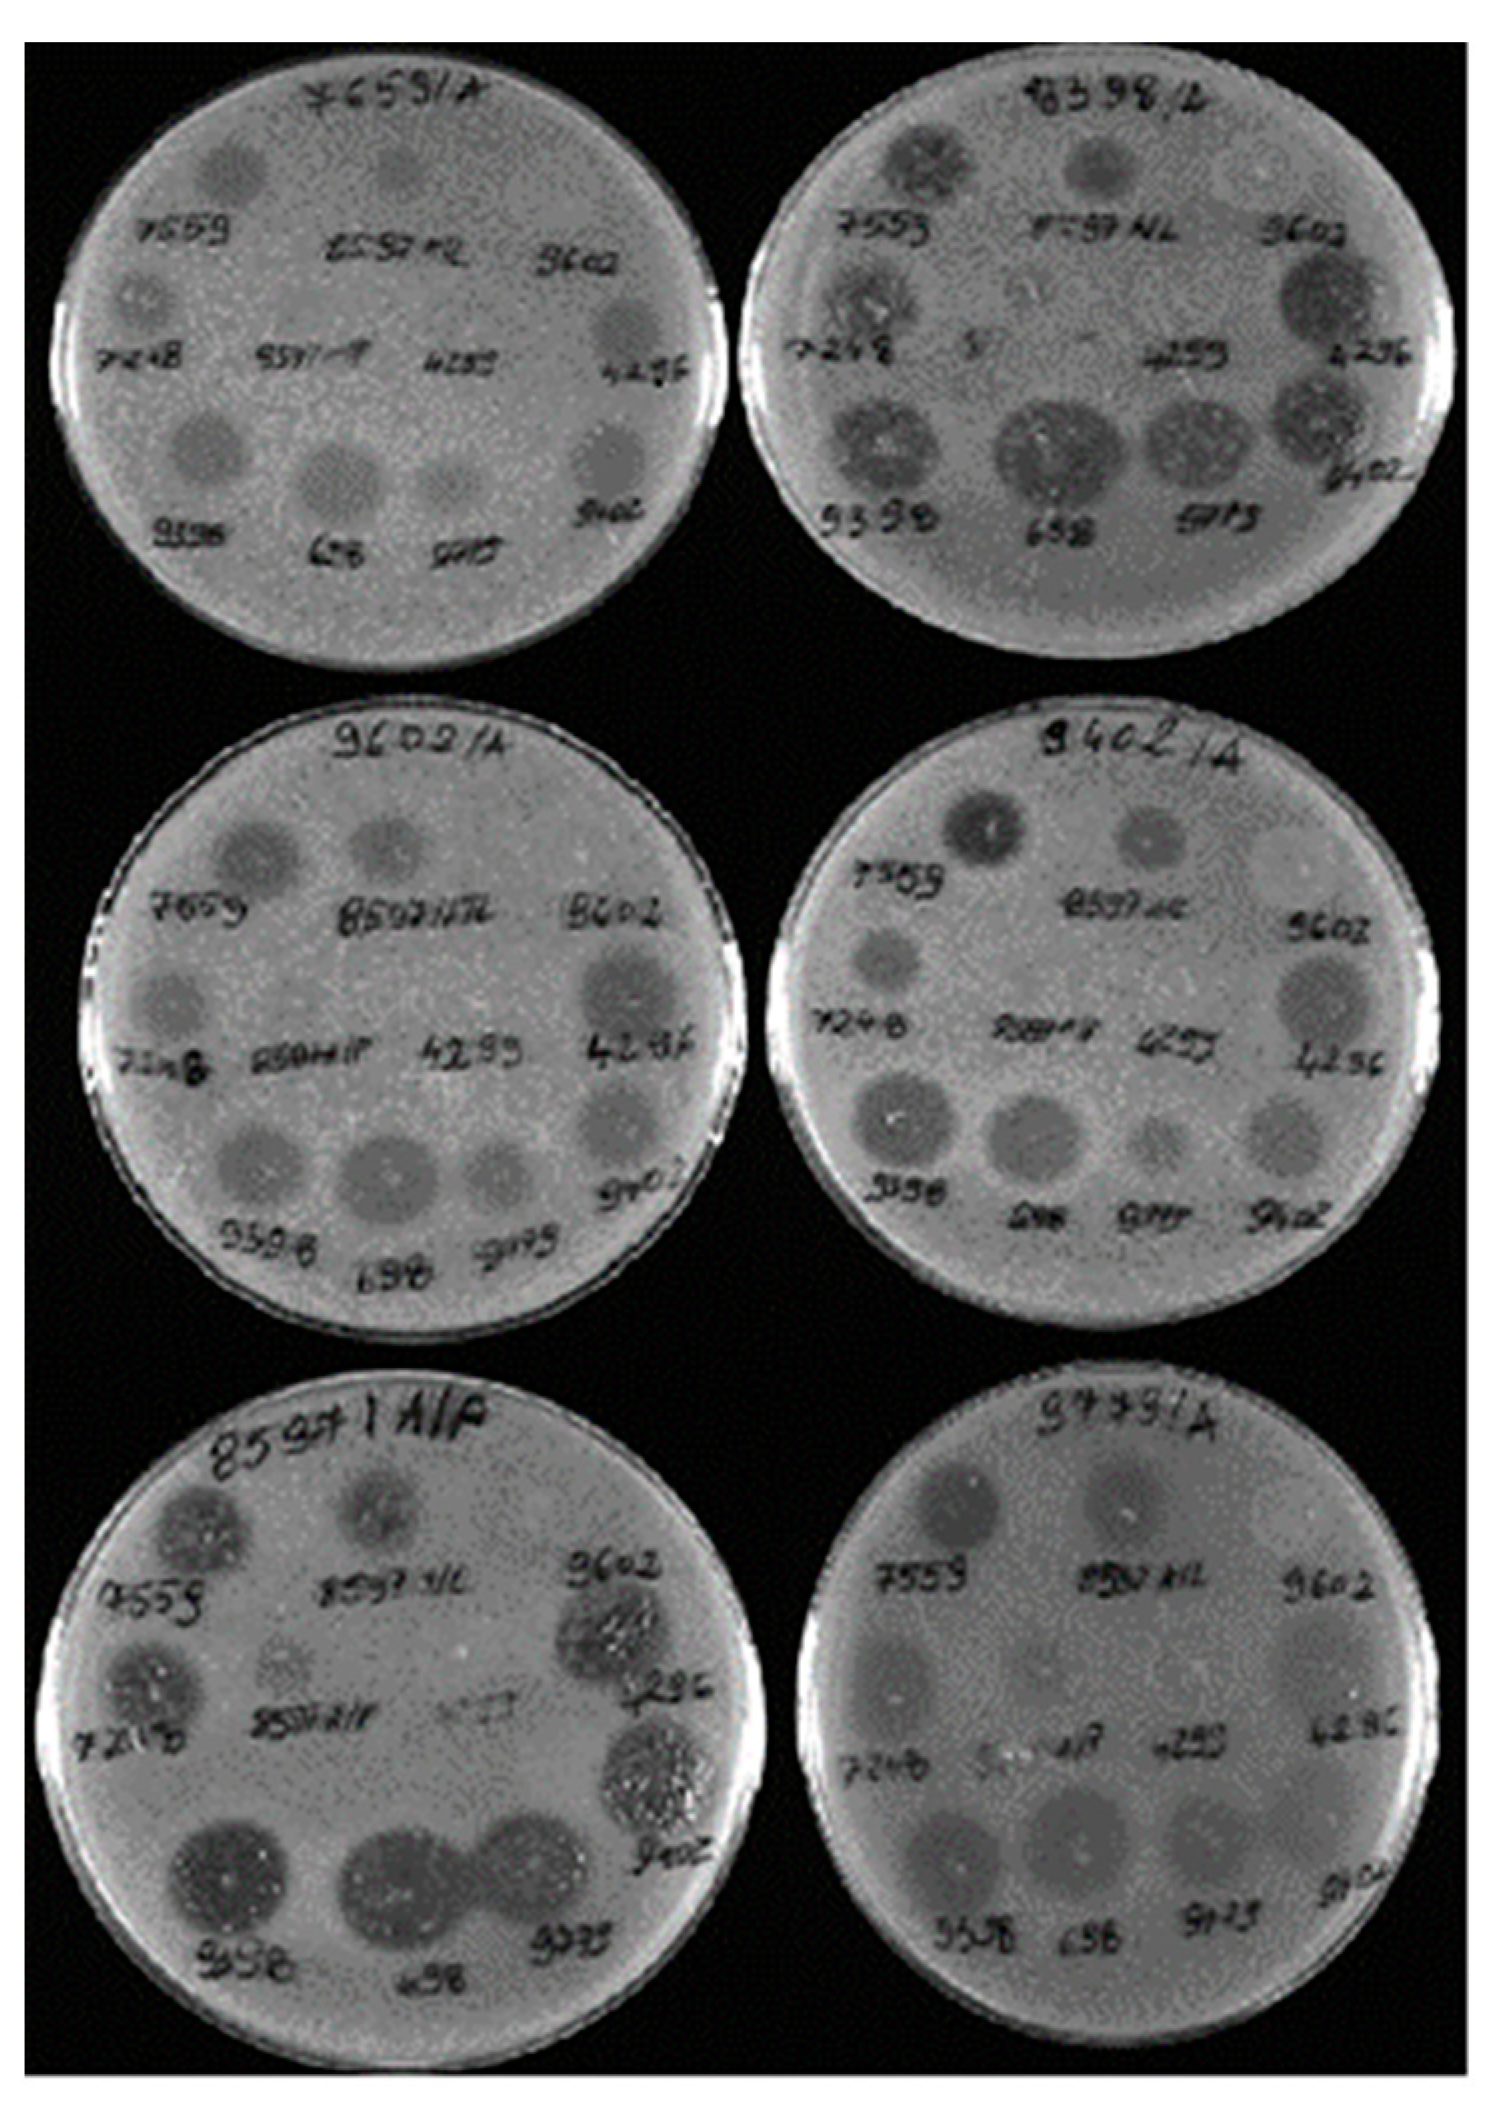
Animals 14 00683 g003

Bacteriophages for Controlling Staphylococcus spp. Pathogens on Dairy Cattle Farms: In Vitro Assessment
Abstract
Simple Summary
Abstract
1. Introduction
2. Materials and Methods
2.1. Isolation of Staphylococcus spp. Strains
2.2. Identification of Staphylococcus spp. Strains by Multiplex PCR and Antibiotic Resistance Profiles
2.3. Isolation and Characterization of Bacteriophages Specific for Isolated Staphylococcus spp. Strains
2.4. Assessment of the In Vitro Antibacterial Effect of the Bacteriophages against Staphylococcus spp. Strains Isolated from Cattle
3. Results
3.1. Isolation and Identification of Bacteria
3.2. Analysis of the Drug Resistance Profiles of Staphylococcus spp. Bacteria Isolated from Cases of Lameness in Dairy Cattle
3.3. Results of Isolation and Characterization of Bacteriophages Specific for S. aureus and S. sciuri Strains Isolated from Cattle with Signs of Lameness
3.4. Restriction Analysis of Bacteriophages Specific for Staphylococcus spp. Using the Enzymes EcoRI, NotI, HindIII, and BSU15I
3.5. Analysis of the Spectrum of Lytic Activity of the Three Bacteriophages with the Broadest Host Range
4. Discussion
5. Conclusions
Author Contributions
Funding
Institutional Review Board Statement
Informed Consent Statement
Data Availability Statement
Conflicts of Interest
References
- Refaai, W.; Van Aert, M.; Abd El-Aal, A.M.; Behery, A.E.; Opsomer, G. Infectious diseases causing lameness in cattle with a main emphasis on digital dermatitis (Mortellaro disease). Livest. Sci. 2013, 156, 53–63. [Google Scholar] [CrossRef]
- Kasela, M.; Ossowski, M.; Dzikoń, E.; Ignatiuk, K.; Wlazło, Ł.; Malm, A. The Epidemiology of Animal-Associated Methicillin-Resistant Staphylococcus aureus. Antibiotics 2023, 12, 1079. [Google Scholar] [CrossRef]
- McAuley, C.M.; McMillan, K.; Moore, S.C.; Fegan, N.; Fox, E.M. Prevalence and characterization of foodborne pathogens from Australian dairy farm environments. J. Dairy Sci. 2014, 97, 12. [Google Scholar] [CrossRef] [PubMed]
- Zakary, E.M.; Nassif, M.Z.; Mohammed, G.M. Detection of Staphylococcus aureus in bovine milk and its product by real time PCR assay. GJBBR 2011, 6, 171–177. [Google Scholar]
- Simpson, K.M.; Streeter, R.N.; Jones, M.L.; Taylor, J.D.; Callan, R.J.; Holt, T.N. Review of digital anatomy, infectious causes of lameness, and regional intravenous perfusion in cattle. Bov. Pract. 2020, 54, 17–29. [Google Scholar] [CrossRef]
- Garvey, M. Lameness in Dairy Cow Herds: Disease Aetiology, Prevention and Management. Dairy 2022, 3, 199–210. [Google Scholar] [CrossRef]
- Dolecheck, K.; Bewley, J. Animal board invited review: Dairy cow lameness expenditures, losses and total cost. Animal 2018, 12, 1462–1474. [Google Scholar] [CrossRef]
- Barkema, H.W.; Schukken, Y.H.; Zadoks, R.N. Invited Review: The role of cow, pathogen, and treatment regimen in the therapeutic success of bovine Staphylococcus aureus mastitis. J. Dairy Sci. 2006, 89, 1877–1895. [Google Scholar] [CrossRef]
- Velasco, V.; Alejandra Mallea, A.; Bonilla, A.M.; Cmpos, J.; Rojas-García, P. Antibiotic-Resistance Profile of Staphylococcus Aureus Strains In The Pork Supply Chain. Chil. J. Agric. Anim. Sci. 2022, 38, 234–240. [Google Scholar] [CrossRef]
- França, C.A.; Peixoto, R.M.; Cavalcante, M.B.; Melo, N.F.; Oliveira, C.J.B.; Veschi, J.L.A.; Mota, R.A.; Costa, M.M. Antimicrobial resistance of Staphylococcus spp. from small ruminant mastitis in Brazil. Pesq. Vet. Bras. 2012, 32, 747–753. [Google Scholar] [CrossRef]
- Rafailidis, P.I.; Kofteridis, D. Proposed amendments regarding the definitions of multidrug-resistant and extensively drug-resistant bacteria. Expert Rev. Anti-Infect. Ther. 2022, 20, 139–146. [Google Scholar] [CrossRef]
- Urban-Chmiel, R.; Marek, A.; Stępień-Pyśniak, D.; Wieczorek, K.; Dec, M.; Nowaczek, A.; Osek, J. Antibiotic Resistance in Bacteria—A Review. Antibiotics 2022, 11, 1079. [Google Scholar] [CrossRef]
- Chen, Q.; Xie, S.; Lou, X.; Cheng, S.; Liu, X.; Zheng, W.; Zheng, Z.; Wang, H. Biofilm formation and prevalence of adhesion genes among Staphylococcus aureus isolates from different food sources. Microbiologyopen 2020, 9, e00946. [Google Scholar] [CrossRef] [PubMed]
- Kaczorek-Łukowska, E.; Małaczewska, J.; Sowińska, P.; Szymańska, M.; Wójcik, E.A.; Siwicki, A.K. Staphylococcus aureus from Subclinical Cases of Mastitis in Dairy Cattle in Poland, What Are They Hiding? Antibiotic Resistance and Virulence Profile. Pathogens 2022, 11, 1404. [Google Scholar] [CrossRef] [PubMed]
- Dias, R.S.; Eller, M.R.; Duarte, V.S.; Pereira, A.L.; Silva, C.C.; Mantovani, H.C.; Oliveira, L.L.; de AM Silva, E.; De Paula, S.O. Use of phages against antibiotic-resistant Staphylococcus aureus isolated from bovine mastitis. J. Anim. Sci. 2013, 91, 3930–3939. [Google Scholar] [CrossRef] [PubMed]
- Regulation EU 2019/6 of the European Parliament and of the Council of 11 December 2018 on Veterinary Medicinal Products and Repealing Directive 2001/82/EC (Text with EEA relevance) PE/45/2018/REV/1. Off. J. Eur. Union 2019, L4, 43–167. Available online: http://data.europa.eu/eli/reg/2019/6/oj (accessed on 28 January 2022).
- Batinovic, S.; Wassef, F.; Knowler, S.A.; Rice, D.T.F.; Stanton, C.R.; Rose, J.; Tucci, J.; Nittami, T.; Vinh, A.; Drummond, G.R.; et al. Bacteriophages in natural and artificial environments. Pathogens 2019, 8, 100. [Google Scholar] [CrossRef] [PubMed]
- Keen, E.C.; Dantas, G. Close encounters of three kinds: Bacteriophages, commensal bacteria, and host immunity. Trends Microbiol. 2018, 26, 943–954. [Google Scholar] [CrossRef] [PubMed]
- Dec, M.; Wernicki, A.; Urban-Chmiel, R. Efficacy of experimental phage therapies in livestock. Anim. Health Res. Rev. 2020, 21, 69–83. [Google Scholar] [CrossRef]
- Alomari, M.M.M.; Dec, M.; Nowaczek, A.; Puchalski, A.; Wernicki, A.; Kowalski, C.; Urban-Chmiel, R. Therapeutic and Prophylactic Effect of the Experimental Bacteriophage Treatment to Control Diarrhea Caused by E. coli in Newborn Calves. ACS Infect Dis. 2021, 7, 2093–2101. [Google Scholar] [CrossRef]
- Guo, M.; Gao, Y.; Xue, Y.; Liu, Y.; Zeng, X.; Cheng, Y.; Ma, J.; Wang, H.; Sun, J.; Wang, Z.; et al. Bacteriophage Cocktails Protect Dairy Cows Against Mastitis Caused by Drug Resistant Escherichia coli Infection. Front. Cell Infect. Microbiol. 2021, 11, 690377. [Google Scholar] [CrossRef] [PubMed]
- Urban-Chmiel, R.; Balicki, I.; Świąder, K.; Nowaczek, A.; Pyzik, E.; Stępień-Pyśniak, D.; Marek, A.; Puchalski, A.; Wernicki, A.; Poleszak, E.; et al. The in vitro efficacy of eye drops containing a bacteriophage solution specific for Staphylococcus spp. isolated from dogs with bacterial conjunctivitis. Ir. Vet. J. 2020, 73, 21. [Google Scholar] [CrossRef] [PubMed]
- Marek, A.; Stępień-Pyśniak, D.; Pyzik, E.; Adaszek, Ł.; Wilczyński, J.; Winiarczyk, S. Occurrence and characterization of Staphylococcus bacteria isolated from poultry in Western Poland. Berl. Münch. Tierärztl. Wochensch. 2016, 129, 147–152. [Google Scholar]
- Marek, A.; Pyzik, E.; Stępień-Pyśniak, D.; Urban-Chmiel, R.; Jarosz, Ł.S. Association between the Methicillin Resistance of Staphylococcus aureus Isolated from Slaughter Poultry, Their Toxin Gene Profiles and Prophage Patterns. Curr. Microbiol. 2018, 75, 1256–1266. [Google Scholar] [CrossRef] [PubMed]
- Jahan, M.; Rahman, M.; Parvej, M.S.; Chowdhury, Z.H.; Haque, E.; Talukder, A.K.; Ahmed, S. Isolation and characterization of Staphylococcus aureus from raw cow milk in Bangladesh. J. Adv. Vet. Anim. Res. 2015, 2, 49–55. [Google Scholar] [CrossRef]
- Jurczak-Kurek, A.; Gąsior, T.; Nejman-Faleńczyk, B.; Bloch, S.; Dydecka, A.; Topka, G.; Necel, A.; Jakubowska-Deredas, M.; Narajczyk, M.; Richert, M.; et al. Biodiversity of bacteriophages: Morphological and biological properties of a large group of phages isolated from urban sewage. Sci. Rep. 2016, 6, 34338. [Google Scholar] [CrossRef]
- Marek, A.; Pyzik, E.; Stępień-Pyśniak, D.; Urban-Chmiel, R.; Nowaczek, A. Characterization of bacteriophages and their carriage in Staphylococcus aureus isolated from broilers in Poland. Br. Poult. Sci. 2019, 60, 373–380. [Google Scholar] [CrossRef]
- Fokine, A.; Rossmann, M.G. Molecular architecture of tailed double-stranded DNA phages. Bacteriophage 2014, 4, e28281. [Google Scholar] [CrossRef]
- Litt, P.K.; Saha, J.; Jaroni, D. Characterization of Bacteriophages Targeting Non-O157 Shiga Toxigenic Escherichia coli. J. Food Prot. 2018, 81, 785–794. [Google Scholar] [CrossRef]
- Turner, D.; Shkoporov, A.N.; Lood, C.; Millard, A.D.; Dutilh, B.E.; Alfenas-Zerbini, P.; van Zyl, L.J.; Aziz, R.K.; Oksanen, H.M.; Poranen, M.M.; et al. Abolishment of morphology-based taxa and change to binomial species names: 2022 taxonomy update of the ICTV bacterial viruses subcommittee. Arch. Virol. 2023, 168, 74. [Google Scholar] [CrossRef]
- ICTV. 2022. Available online: https://ictv.global/ (accessed on 1 July 2022).
- Urban-Chmiel, R.; Stachura, R.; Hola, P.; Pyzik, E.; Dec, M.; Nowaczek, A.; Puchalski, A.; Herman, K. Efekty oddziaływania eksperymentalnego preparatu ziołowo-fagowego do pielęgnacji racic u krów mlecznych jako możliwości poprawy dobrostanu cieląt. Lecz. Dużych Zwierząt 2022, 1, 42–49. [Google Scholar]
- Archer, S.C.; Green, M.J.; Huxley, J.N. Association between milk yield and serial locomotion score assessments in UK dairy cows. J. Dairy Sci. 2010, 93, 4045–4053. [Google Scholar] [CrossRef]
- Miciński, B.; Miciński, J. Selected cattle hoof diseases: Characteristics, consequences, control and prevention. Pol. J. Nat. Sci. 2019, 34, 297–315. [Google Scholar]
- Monecke, S.; Kuhnert, P.; Hotzel, H.; Slickers, P.; Ehricht, R. Microarray based study on virulence-associated genes and resistance determinants of isolates from cattle. Vet. Microbiol. 2007, 125, 128. [Google Scholar] [CrossRef]
- Patterson, J.A.; Amick, R.Z.; Thummar, T.; Rogers, M.E. Validation of measures from the smartphone sway balance application: A pilot study. Int. J. Sports Phys. Ther. 2014, 9, 135–139. [Google Scholar] [PubMed]
- Keyvan, E.; Yurdakul, O.; Demirtas, A.; Yalcin, H.; Bilgen, N. Identification of Methicillin-Resistant Staphylococcus aureus in Bulk Tank Milk. Food Sci. Technol. 2020, 40, 150–156. [Google Scholar] [CrossRef]
- Rychshanova, R.; Mendybayeva, A.; Miciński, B.; Mamiyev, N.; Shevchenko, P.; Bermukhametov, Z.; Orzechowski, B.; Miciński, J. Antibiotic resistance and biofilm formation in Staphylococcus aureus isolated from dairy cows at the stage of subclinical mastitis in northern Kazakhstan. Arch. Anim. Breed. 2022, 65, 439–448. [Google Scholar] [CrossRef]
- Jończyk, E.; Kłak, M.; Międzybrodzki, R.; Górski, A. The influence of external factors on bacteriophages—Review. Folia Microbiol. 2011, 56, 191–200. [Google Scholar] [CrossRef]
- Mishra, A.K.; Sharma, N.; Kumar, A.; Kumar, N.; Gundallahalli Bayyappa, M.R.; Kumar, S.; Kumar, N. Isolation, characterization and therapeutic potential assessment of bacteriophages virulent to Staphylococcus aureus associated with goat mastitis. Iran J. Vet. Res. 2014, 15, 320–325. [Google Scholar]
- O’Flaherty, S.; Ross, R.P.; Flynn, J.; Meaney, W.J.; Fitzgerald, G.F.; Coffey, A. Isolation and characterization of two anti-staphylococcal bacteriophages specific for pathogenic Staphylococcus aureus associated with bovine infections. Lett. Appl. Microbiol. 2005, 41, 482–486. [Google Scholar] [CrossRef]
- Leite, J.A.; Pereira, H.P.; Borges, C.A.V.; Alves, B.R.C.; Ramos, A.I.A.P.; Martins, M.F.; Arcuri, E.F. Lytic bacteriophages as a potential alternative to control Staphylococcus aureus. Pesqui. Agropecuária Bras. 2019, 54, e00917. [Google Scholar] [CrossRef]
- Titze, I.; Lehnherr, T.; Lehnherr, H.; Krömker, V. Efficacy of Bacteriophages Against Staphylococcus aureus Isolates from Bovine Mastitis. Pharmaceuticals 2020, 13, 35. [Google Scholar] [CrossRef] [PubMed]
- Ngassam-Tchamba, C.; Duprez, J.N.; Fergestad, M.; De Visscher, A.; L’Abee-Lund, T.; De Vliegher, S.; Wasteson, Y.; Touzain, F.; Blanchard, Y.; Lavigne, R.; et al. In Vitro and in Vivo Assessment of Phage Therapy against Staphylococcus Aureus Causing Bovine Mastitis. J. Glob. Antimicrob. Resist. 2020, 22, 762–770. [Google Scholar] [CrossRef]
- Mohammadian, F.; Rahmani, H.K.; Bidarian, B.; Khoramian, B. Isolation and evaluation of the efficacy of bacteriophages against multidrug-resistant (MDR), methicillin-resistant (MRSA) and biofilm-producing strains of Staphylococcus aureus recovered from bovine mastitis. BMC Vet. Res. 2022, 18, 406. [Google Scholar] [CrossRef]
- Loc-Carrillo, C.; Abedon, S.T. Pros and cons of phage therapy. Bacteriophage 2011, 2, 111–114. [Google Scholar] [CrossRef] [PubMed]
- Malik, D.J.; Sokolov, I.J.; Vinner, G.K.; Mancuso, F.; Cinquerrui, S.; Vladisavljevic, G.T.; Clokie, M.R.J.; Garton, N.J.; Stapley, A.G.F.; Kirpichnikova, A. Formulation, stabilisation and encapsulation of bacteriophage for phage therapy. Adv. Colloid Interface Sci. 2017, 249, 100–133. [Google Scholar] [CrossRef] [PubMed]
- Gill, J.J.; Pacan, J.C.; Carson, M.E.; Leslie, K.E.; Griffiths, M.W.; Sabour, P.M. Efficacy and pharmacokinetics of bacteriophage therapy in treatment of subclinical Staphylococcus aureus mastitis in lactating dairy cattle. Antimicrob. Agents Chemother. 2006, 50, 2912–2918. [Google Scholar] [CrossRef]
- Gill, J.J.; Sabour, P.M.; Leslie, K.E.; Griffiths, M.W. Bovine whey proteins inhibit the interaction of Staphylococcus aureus and bacteriophage K. J. Appl. Microbiol. 2006, 101, 377–386. [Google Scholar] [CrossRef]

| Farm Number | Number of Samples Collected from Floor | Number of Cows from Which Samples Were Taken | Number of Cows with Two Injured Limbs | Total Number of Samples Collected from Cows |
|---|---|---|---|---|
| Farm 1 | 1 | 10 | 2 | 12 |
| Farm 2 | 1 | 11 | 3 | 14 |
| Farm 3 | 1 | 11 | 0 | 11 |
| Farm 4 | 1 | 10 | 2 | 12 |
| Farm 5 | 1 | 7 | 0 | 7 |
| Total | 5 | 49 | 7 | 56 |
| Log (Score) | Description | Symbol | Number of Strains | ||
|---|---|---|---|---|---|
| Staphylococcus aureus | Staphylococcus sciuri | Providencia stuartii | |||
| 2.000–2.299 | Secure genus identification and probable species identification | ++ | 13 | 15 | 0 |
| 1.700–1.999 | Probable genus identification | + | 11 | 13 | 2 |
| <1.700 | No reliable identification | − | 0 | 0 | 0 |
| Strain No. | Antibiotic | |||||||||
|---|---|---|---|---|---|---|---|---|---|---|
| TE | NEO | ENR | CXM | AMX | SPC | VA | TOB | DA | CIP | |
| 2257 | S | R | R | S | S | R | S | S | S | S |
| 3324 | S | R | R | S | R | R | S | S | S | S |
| 8534 | I | R | R | S | R | R | I | S | R | S |
| 9228 | I | R | R | S | S | R | S | S | S | R |
| 6036 | I | R | R | S | S | R | S | S | I | S |
| 6019 | R | R | I | I | S | S | R | S | R | S |
| 4296 | S | R | R | S | I | R | I | S | R | R |
| 7559 | I | R | R | S | S | R | R | R | S | S |
| 8597/L | I | R | R | S | S | S | S | R | R | R |
| 8597/P | I | R | I | I | S | R | S | R | I | S |
| 9602 | R | R | R | S | I | R | S | R | I | R |
| 9402 | I | R | I | I | S | R | S | S | S | I |
| 9779 | I | R | R | S | R | R | S | S | S | R |
| 698 | I | R | R | S | R | R | S | R | S | I |
| 3052 | R | R | R | R | R | R | S | R | S | R |
| 9400 | I | S | R | S | S | R | I | I | R | I |
| Phage No. | Bacterial Strain No. | Bacterial Species Used for Bacteriophage Isolation | Bacteriophage Family | Lytic Titre of Phage | Bacterial Host Range | |
|---|---|---|---|---|---|---|
| 1. | 7559 | 7559 | S. sciuri | Siphoviridae-like | 1.8 × 10−5 PFU/mL | 8597/P, 9402, 9779, 9398, 9602, 7559, 698 |
| 2. | 8597/P | 8597/P | S. sciuri | Siphoviridae-like | 2.2 × 10−8 PFU/mL | 8597/P, 7559, 9779 |
| 3. | 8597/L | 8597/L | S. aureus | Myoviridae-like | 1.6 × 10−7 PFU/mL | 8597/P, 8597/L, 9402, 7559, 9779, 4296, 9602, 9398, 22557, 6036, 3324, 9228, 6019, 3324, 8534, 698 |
| 4. | 7248 | 7248 | S. sciuri | Siphoviridae-like | 1.9 × 10−2 PFU/mL | 8597/P, 9402, 7559, 9779, 9602, 698, 3324 |
| 5. | 4296 | 4296 | S. sciuri | Myoviridae-like | 1.8 × 10−8 PFU/mL | 8597/P, 8597/L, 7559, 9402, 9779, 9602, 9398, 22557, 6036, 3324, 9228, 6019, 4296, 698, 4296, 698 |
| 6. | 9398 | 698 | S. aureus | Myoviridae-like | 1.4 × 10−5 PFU/mL | 8597/P, 8597/L, 4299, 9779, 4296, 9602, 9398, 22557, 6036, 3324, 9228, 6019, 7559, 3324, 698, 9402 |
| 7. | 698 | 9398 | S. sciuri | Myoviridae-like | 1.2 × 10−2 PFU/mL | 8597/P, 9402, 7559, 9779 |
| 8. | 9779 | 9779 | S. aureus | Siphoviridae-like | 1.8 × 10−1 PFU/mL | 8597/P, 4299, 7559, 4296 |
| 9. | 9402 | 9402 | S. sciuri | Siphoviridae-like | 2.1 × 10−3 PFU/mL | 8597/P, 7559, 9779, 9602 |
| 10. | 9602 | 9602 | S. sciuri | Siphoviridae-like | 2.3 × 10−1 PFU/mL | 9602, 3324 |
| 11. | 9228 | 9228 | S. sciuri | Siphoviridae-like | 1.6 × 10−2 PFU/mL | 22557, 6019, 6036, 9228, 8534, 698, 3324 |
| 12. | 8534 | 8534 | S. sciuri | Myoviridae-like | 1.2 × 10−2 PFU/mL | 8534, 3324, 6036 |
| 13. | 6019 | 6019 | S. sciuri | Siphoviridae-like | 1.2 × 10−4 PFU/mL | 3324, 9228 |
| 14. | 6036 | 6036 | S. sciuri | Siphoviridae-like | 1.2 × 10−4 PFU/mL | 3324, 22557 |
| 15. | 22557 | 22557 | S. aureus | Myoviridae-like | 1.6 × 10−2 PFU/mL | 3324, 22557, 9228, 6036, 698,8534, 3324 |
| 16. | 3324 | 3324 | S. sciuri | Myoviridae-like | 1.2 × 10−2 PFU/mL | 6036, 3324 |
| Bacteriophage No. | Percentage (%) Lytic Activity against 69 Staphylococcus spp. Strains | ||
|---|---|---|---|
| S. aureus (n = 36) | S. sciuri (n = 19) | S. epidermidis (n = 14) | |
| 8597/L | 88.9 | 100 | 100 |
| 4296 | 94.4 | 78.9 | 100 |
| 698 | 86.1 | 100 | 100 |
Disclaimer/Publisher’s Note: The statements, opinions and data contained in all publications are solely those of the individual author(s) and contributor(s) and not of MDPI and/or the editor(s). MDPI and/or the editor(s) disclaim responsibility for any injury to people or property resulting from any ideas, methods, instructions or products referred to in the content. |
© 2024 by the authors. Licensee MDPI, Basel, Switzerland. This article is an open access article distributed under the terms and conditions of the Creative Commons Attribution (CC BY) license (https://creativecommons.org/licenses/by/4.0/).
Share and Cite
Pyzik, E.; Urban-Chmiel, R.; Kurek, Ł.; Herman, K.; Stachura, R.; Marek, A. Bacteriophages for Controlling Staphylococcus spp. Pathogens on Dairy Cattle Farms: In Vitro Assessment. Animals 2024, 14, 683. https://doi.org/10.3390/ani14050683
Pyzik E, Urban-Chmiel R, Kurek Ł, Herman K, Stachura R, Marek A. Bacteriophages for Controlling Staphylococcus spp. Pathogens on Dairy Cattle Farms: In Vitro Assessment. Animals. 2024; 14(5):683. https://doi.org/10.3390/ani14050683
Chicago/Turabian StylePyzik, Ewelina, Renata Urban-Chmiel, Łukasz Kurek, Klaudia Herman, Rafał Stachura, and Agnieszka Marek. 2024. "Bacteriophages for Controlling Staphylococcus spp. Pathogens on Dairy Cattle Farms: In Vitro Assessment" Animals 14, no. 5: 683. https://doi.org/10.3390/ani14050683
APA StylePyzik, E., Urban-Chmiel, R., Kurek, Ł., Herman, K., Stachura, R., & Marek, A. (2024). Bacteriophages for Controlling Staphylococcus spp. Pathogens on Dairy Cattle Farms: In Vitro Assessment. Animals, 14(5), 683. https://doi.org/10.3390/ani14050683

